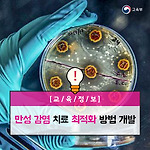

목록2018/01/30 (15)
교육부 공식 블로그
 우리 전통에 나타난 창의성(1) : 추사체에 나타난 창의성 스토리
우리 전통에 나타난 창의성(1) : 추사체에 나타난 창의성 스토리
추사와 추사체 추사체로 유명한 추사(秋史) 김정희(金正喜, 1786, 정조10∼1856, 철종7)는 실사구시(實事求是)에 근거하여 금석학과 고증학 분야의 업적을 많이 남긴 실학자이다. 그는 당시 서예와 그림에서 이른바 ‘완당(阮堂) 바람’이라고 칭해질 정도로 문화 흐름을 주도한 예술가로, 개성과 창의성을 지닌 인물이기도 하다. 추사의 생애에서 제주 유배 9년의 생활은 삶에 대한 철학, 이로 인해 서체가 변화하는 계기가 될 정도로 제주의 삶은 추사의 인생에서 중요한 의미가 있다. 추사체는 매우 예술적이고 창의적인 글씨로 알려져 있다. 추사체의 특성을 말할 때 ‘괴(怪)’와 ‘졸(拙)’로 묘사할 수 잇다. ‘괴’가 추사체의 개성이라면, ‘졸’은 ‘괴’의 부정적 측면을 극복한, 노자의 이른바 ‘대교약졸(大巧若..
 Learning-by-Doing 참여적 과학 프로젝트 수행하기: IQWST 프로그램 사례
Learning-by-Doing 참여적 과학 프로젝트 수행하기: IQWST 프로그램 사례
미국의 University of Michigan, Northwestern University, Michigan State University, the Weizmann Institute of Science 등 다양한 과학 교육자들의 참여로 개발된 Investigating and Questioning our World Through Science and Technology(이하 IQWST) 프로그램은 청소년기의 학생들을 과학자로 키우기 위한 과학 교육 프로그램이다. IQWST 프로그램에서 학생들은 일상 생활과 관련된 여러 실질적인 문제들을 조사하고, 관련 자료를 조사하고, 모으고 분석하며, 현상을 설명하기 위한 나만의 모델을 만드는 프로젝트 기반 학습에 참여한다. 특히 NGSS를 근간으로 개발된 IQWST는..
 사이버 위협, ‘정보공유’와 ‘기계학습’으로 해결
사이버 위협, ‘정보공유’와 ‘기계학습’으로 해결
사이버 위협, ‘정보공유’와 ‘기계학습’으로 해결 지능형 위협 정보로 악성코드 분석 국내 보안 사고가 심심치 않게 들려온다. 지난 해에는 금전 이득 목적으로 비트코인 거래소를 공격한 사건이 자주 발생했다. 보안 시스템은 네트워크를 검열한다. 그런데도 보안 시스템이 악성코드를 탐지하지 못하는 이유는 무엇일까? 보안 시스템을 우회하는 악성코드가 있기 때문이다. 이는 보안 업계의 가장 큰 고민거리이다. 해커는 악성코드를 숨기기 위해 우회 수단을 쓴다. 대표적으로 ‘네트워크 암호화’가 우회 방법에 해당한다. 최근 네트워크 암호화를 악용해서 악성코드를 숨기는 경우가 늘어나고 있는데, 이는 보안 시스템이 네트워크의 내용을 검열할 수 없게 한다. 모든 네트워크를 보안 시스템이 검열할 수 없다. ⓒ DoN CIO 악성..
 만성 감염 치료 최적화 방법 개발
만성 감염 치료 최적화 방법 개발
만성 감염 치료 최적화 방법 개발 약효 반응 유발하는 돌연변이 식별 항생제 내성균을 퇴치할 수 있는 새 전략이 제시됐다. 덴마크 과학기술대 연구진은 낭포성 섬유증 환자에게 감염된 항생제 내성 슈도모나스균이 다른 종류의 항생제에 예측 가능한 치료 감수성을 보인다는 사실을 발견, 이 특성을 이용해 다제 내성균에 의한 만성 감염 치료를 최적화할 수 있는 새로운 방법을 개발했다고 생명과학저널 ‘셀’(Cell)지 최근호에 발표했다. 이 대학 노보 노르디스크 생물지속가능성 센터 연구책임자인 모르텐 소머(Morten Sommer) 교수는 “이번 연구를 통해 다제 내성 병원균인 슈도모나스균(Pseudomonas aeruginosa)에서 광범위한 항생제 감수성을 발견한 것은 항생제 내성이 확산되는 것을 막고 이를 되돌릴..
 STEAM 교육과 창의교육
STEAM 교육과 창의교육
STEAM 교육과 창의교육 4차 산업혁명 시대를 대비하는 새로운 교육의 패러다임 ‘Science’, ‘Technology’, ‘Engineering’, ‘Arts’, ‘Mathematics’의 약자로, 과학기술에 대한 학생의 흥미와 이해를 높이고 과학기술기반의 융·복합적 사고력과 창의력을 배양하는 교육을 일컫는 ‘STEAM 교육’은 많은 이들에게 더 이상 낯선 개념이 아닐 것입니다. 빠르게 변화하는 미래교육에 발맞춰 나아가고자 교육기부의 신규 분야 발굴의 필요성을 느낀 교육부와 한국창의재단은 ‘대학생과 함께하는 창의융합형 STEAM 교육기부’ 사업을 운영하고 있습니다. 교육부와 한국창의재단의 ‘대학생과 함께하는 창의융합형 STEAM 교육기부’ 홍보 포스터 특히 STEAM형의 교육기부의 경우 교·사대 대학..
 우리 손으로 직접 학교에 소녀상을 건립했어요
우리 손으로 직접 학교에 소녀상을 건립했어요
우리 손으로 직접 학교에 소녀상을 건립했어요 리얼 혁신 학교 3탄 2018년 1월 18일, 인천 동구에 위치한 서흥초등학교에서 뜻깊은 행사가 개최되었다. 작년 7월 전교학생회 안건으로 채택되어, 약 6개월 간 6학년 학생들을 중심으로 전교생이 참여한 ‘서흥초등학교 평화의 소녀상 건립 제막식’이 서흥초등학교 도서관에서 열려 현장을 방문했다. 평화의 소녀상이란 일본군 위안부 문제의 피해를 상징하는 상징물이다. 일본군 위안부 문제 해결을 촉구하는 의미에서 세운 동상으로 한국정신대문제대책협의회(정대협)가 중심이 돼 서울 종로 주한 일본 대사관 앞에 처음 설치했다. 서흥초등학교는 2015년 3월, 주입식 교육의 틀에서 벗어나 학생의 자발적인 참여를 유도하여 창의적인 인재를 육성하는 ‘행복배움학교’(인천형 혁신학교..
초등학교에서 변화하는 교육, 2015 개정교육과정
초등학교에서 변화하는 교육, 2015 개정교육과정
초등학교에서 변화하는 교육, 2015 개정교육과정 2015 개정교육과정의 등장 배경 2017년, 초등학교 1~2학년을 대상으로 2015 개정교육과정이 교육현장에 적용되기 시작했다. 초등학교를 기준으로 올해는 3~4학년, 내년에는 5~6학년에 개정된 교육과정이 적용됨으로써 초등학교 전 학년에 2015 개정교육과정이 자리 잡게 된다. 교육현장의 기본 틀로 자리매김하고 있는 2015 개정교육과정에 대해 교원 및 학생, 학부모 등이 깊은 관심을 보이고 있다. 그렇다면 2015 개정교육과정이 등장한 배경은 무엇일까? 2015 개정교육과정이 2009 개정교육과정과의 가장 큰 차이점은 '핵심역량'의 도입이라 할 수 있다. 2015 개정교육과정은 ‘6가지 핵심역량’을 강조하고 있으며, 6가지 역량을 함양한 ‘창의 융합..
